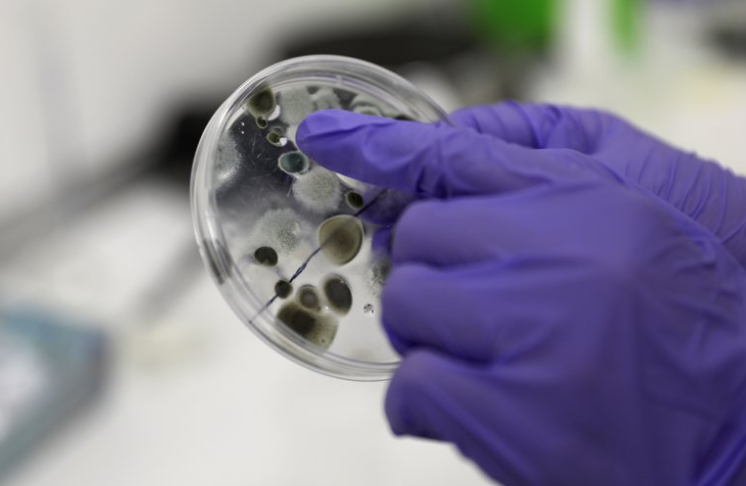
pandemia pandemia.png

A medida que el mundo espera un rápido lanzamiento de las vacunas COVID-19 en 2021, es probable que las ambiciones de los investigadores aún se vean limitadas por la pandemia continua y sus efectos. En medio de las prioridades profesionales cambiantes, Nature pidió a los científicos su consejo para sus colegas y lo que planean comenzar, limitar o seguir haciendo.
Crear límites. Los investigadores en todas las etapas de la carrera cuyo espacio de trabajo sea principal o exclusivamente en casa deben establecer límites firmes en las horas de trabajo, dice Stéphanie Lizy-Destrez, quien estudia el diseño y la función de los futuros sistemas espaciales en el Instituto Superior de Aeronáutica y Espacio en Toulouse, Francia. “El mayor desafío es separar la vida profesional de la privada”, asegura.
El caso de Francia
Cuando Francia impuso el cierre por primera vez en marzo, examinó los impactos del aislamiento en 80 estudiantes de posgrado y pregrado que estaban confinados en sus pequeños dormitorios en el campus. Ella dice que es difícil para las personas que trabajan de forma remota separar el tiempo personal y profesional. “No hay fronteras”, advierte. “A veces no te tomas tiempo para descansar o divertirte”. Además de establecer horarios regulares para despertarse y comer durante la semana, aconseja establecer períodos no negociables para el tiempo libre y el ejercicio, especialmente los fines de semana.
Estrategias científicas
Cuando Heidi Rehm resolvió este año crear una semana sin reuniones una vez al trimestre, no podía haber anticipado la pandemia. Aun así, dice Rehm, directora médica de la Plataforma de Secuenciación de Investigación Clínica del Broad Institute en Cambridge, Massachusetts, no ha resbalado ni una vez. En todo caso, dice, la estrategia ha prosperado: el Broad Institute planea expandirlo en toda la institución el próximo mes.
Los investigadores en todas las etapas de la carrera cuyo espacio de trabajo sea principal o exclusivamente en casa deben establecer límites firmes en las horas de trabajo, dice Stéphanie Lizy-Destrez (REUTERS)Mejorar las interacciones virtuales. Las conferencias en línea nivelan el campo de juego y permiten una mayor asistencia, dice Emmanuel Adukwu, subdirector interino del departamento de ciencias aplicadas de la Universidad del Oeste de Inglaterra en Bristol, Reino Unido, quien dice que convocará a más de ellos en 2021. Cita el éxito del Día de la Carrera anual de 2020 de la Royal Society of Biology, que según él atrajo 5 veces el número habitual de estudiantes asistentes, incluidos 100 de su departamento. “Abren oportunidades a cualquiera que tenga acceso a Internet”, dice sobre las reuniones virtuales, y agrega que benefician a los científicos jóvenes que no pueden pagar el costo de los viajes a conferencias lejanas.
Conferencias por Zoom
La farmacóloga molecular Lauren May de la Universidad de Monash en Melbourne, Australia, explica que ciertas voces pueden dominar las sesiones de conferencias en persona o los debates en el aula. Por el contrario, dice, es más probable que los estudiantes hagan preguntas o agreguen comentarios a la función de chat de una reunión en línea que hablar en un salón de clases o en una conferencia. May recomienda aplicaciones de conferencias que pueden ayudar a los asistentes virtuales a conectarse entre sí durante o después de las sesiones. A ella particularmente le gusta uno llamado Pollev que permite a los usuarios hacer y responder preguntas entre ellos durante una presentación. Dichas herramientas, dice, pueden estimular la conversación de manera más rápida y sencilla que en persona.
Muchas técnicas seguirán
El matemático Jude Kong de la Universidad de York en Toronto, Canadá, planea seguir usando el software de videoconferencia Zoom específicamente para orientar a estudiantes desfavorecidos, a menudo de grupos étnicos minoritarios. Kong, miembro de la recientemente establecida Red Canadiense de Científicos Negros, se ha estado acercando a estudiantes de secundaria y pregrado a través de seminarios web públicos gratuitos como Café Mathematique. Muchos, dice, no están al tanto de las oportunidades de financiamiento para programas de posgrado. “Seguiré usando Zoom para llegar a personas en comunidades desatendidas”, dice. “Quiero animarlos y animarlos a explorar la investigación”. Ha descubierto que los estudiantes a veces tímidos se sienten más confiados al contactarlo virtualmente desde casa que en persona.
La climatóloga Kim Cobb aconseja a los científicos que programen más tiempo del que esperan necesitar para cumplir con las expectativas laborales y las obligaciones familiares (REUTERS)Ajustar las expectativas
La climatóloga Kim Cobb aconseja a los científicos que programen más tiempo del que esperan necesitar para cumplir con las expectativas laborales y las obligaciones familiares. Luchó por mantenerse optimista este año mientras hacía malabares con la enseñanza de tres clases en línea, la educación en el hogar de cuatro niños y el final de una propuesta de subvención de la Fundación Nacional de Ciencias de 770 páginas y 18 millones de dólares, todo en seis meses. “Yo la llamo mi propuesta para la pandemia”, dice Cobb, del Instituto de Tecnología de Georgia en Atlanta. “Ha sido una curva de aprendizaje”.
Abogar por el trabajo a distancia. El trabajo virtual aún puede ser efectivo para estudiantes de doctorado y posdoctorado incluso después de que se levanten las restricciones, afirma Kevin Burgio, quien fue el autor principal de un artículo este año que destacó diez reglas para hacer un puesto postdoctoral remoto. Burgio, quien está terminando su propio trabajo postdoctoral virtual en Connecticut con Environment and Climate Change Canada, un departamento del gobierno canadiense, dice que la comunicación clara entre el miembro del laboratorio y el investigador principal es clave para el éxito.
Detalles granulares
Particularmente importante, dice, es cubrir detalles granulares como cuántas horas dedicar semanalmente a manuscritos o disertaciones. “Tener una conversación directa con su supervisor sobre las expectativas y cómo pueden cambiar es lo más importante”, indica Burgio.
Apoyar el bienestar del equipo. Cobb insta a los investigadores principales a ser conscientes de la dinámica de poder que podría impulsar a los estudiantes a trabajar en el laboratorio para complacer a los supervisores, especialmente si no hay una dirección clara para priorizar su bienestar. Su equipo trabaja desde casa en análisis computacionales y de datos, manuscritos y subvenciones. Para ella, agrega, cualquier disminución potencial en la productividad es menos importante que la salud de los miembros de su laboratorio.
Lee Cronin, químico de la Universidad de Glasgow, Reino Unido, dice que la pandemia es una buena razón para tomarse el tiempo para investigar con mayor impacto. “Escribamos menos y digamos más”, dice Cronin. “Todos están en el mismo barco”.
“La comunidad científica debe alentar a los investigadores a estar presentes para trabajar como puedan en estos tiempos y a valorar sus contribuciones”, dice Cobb (REUTERS)Seguimiento de los efectos profesionales de la pandemia. Cobb pide continuar la recopilación de datos sobre las consecuencias de la pandemia en las científicas académicas y las de grupos étnicos minoritarios. Ella ha visto a colegas, particularmente aquellos que tienen roles de cuidado, retirar sus resúmenes de conferencias, alejarse de propuestas, renunciar a escribir artículos o abandonar oportunidades prestigiosas. Le preocupa que los retrocesos profesionales ahora tengan un impacto perjudicial duradero en la progresión profesional de los investigadores jóvenes.
Recopilación de datos
La información de la recopilación de datos debería informar las estrategias para abordar los sesgos estructurales en el sistema académico, dice Cobb, como extender los paquetes de puesta en marcha o aumentar el proceso de permanencia y revisión. “Tenemos que reconocer firmemente las desigualdades que afectan a las personas todos los días y asegurarnos de que no estamos empujando a las personas permanentemente fuera de la ciencia porque no cumplen con sus propias expectativas”, dice. “Nuestra respuesta no puede ser, ‘Esfuérzate más y aguanta’”. Más bien, dice ella, la comunidad científica debe alentar a los investigadores a estar presentes para trabajar como puedan en estos tiempos y a valorar sus contribuciones.
May insta a los padres científicos, en particular a las mamás, a que tomen notas cuidadosas sobre cómo la pandemia ha afectado directamente el resultado de sus investigaciones. En 2019, May cofundó Her Research Matters, un grupo universitario que apoya el liderazgo equitativo. Ella dice que la documentación que detalla los logros frente a oportunidades perdidas o restringidas puede respaldar las solicitudes de extensiones de subvenciones y becas o anotar paquetes de promoción académica.
:quality(85)//cloudfront-us-east-1.images.arcpublishing.com/infobae/3SBYSBW6H35JZENG55ALMTHXP4.jpg)
Michelle Halls, secretaria de grupo de Her Research Matters y bióloga molecular en la Universidad de Monash, dice que es crucial que los padres científicos cuantifiquen las horas dedicadas a ayudar a los niños con el trabajo escolar y enumeren las oportunidades perdidas para dar conferencias. “Póngalo en términos reales con pérdidas en tiempo real para dejar en claro cómo el tiempo de trabajo ha sido limitado por la pandemia”, dice. Los padres deben registrar fechas específicas de cierres de universidades, prohibiciones de viaje y cierres de escuelas primarias, agrega.
Difundir el conocimiento
El estudiante de doctorado Roger Gonzales, que estudia salud pública en el Centro Médico de la Universidad de Nebraska en Omaha, seguirá trabajando en comunidades marginadas para aumentar la confianza en la ciencia y la conciencia de los efectos de COVID-19 en la salud.
Gonzales, que habla español con fluidez, se dio cuenta de que los vecindarios de Omaha que no hablaban inglés tenían poco acceso a información relacionada con el coronavirus en su propio idioma. Por eso creó infografías en español sobre cómo evitar infecciones, que han aparecido en hospitales y clínicas y en las redes sociales. Continuará sus esfuerzos para distinguir la ciencia de la desinformación, particularmente a medida que las vacunas estén disponibles para poder tranquilizar a los miembros de la comunidad sobre la seguridad de las vacunas. A menudo, dice, “la ciencia se queda en la academia, y eso deja fuera a mucha gente”.
fuente: infobae